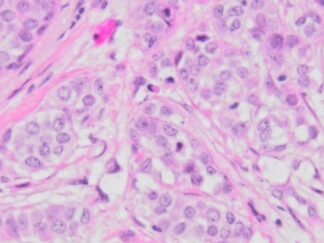

Human Breast Cancer, Triple Positive (ER+/PR+/Her2+), FFPE Sections
Human Triple Positive (ER+PR+HER2+) Breast Cancer is a distinct subtype characterized by the presence of three specific receptors: Estrogen Receptor (ER), Progesterone Receptor (PR), and Human Epidermal Growth Factor Receptor 2 (HER2) in breast cancer cells. This implies that the cancer cells in the breast tissue express receptors for estrogen, progesterone, and HER2.
In the realm of breast cancer, the status of these receptors holds critical importance in determining treatment strategies. In Triple Positive cases, cancer cells respond to hormones such as estrogen and progesterone, along with the HER2 protein. This valuable information guides medical professionals in tailoring therapies that specifically target these receptors, such as hormone therapy or HER2-targeted therapies.
Understanding the molecular characteristics of breast cancer, particularly its receptor status, is pivotal in developing personalized and effective treatment plans for individuals diagnosed with Triple Positive breast cancer.
VitroVivo Bitech provides the FFPE sections of human triple positive (ER+PR+HER2+) breast cancer to enhance your breast cancer research. These human breast cancer FFPE sections are mounted on positively charged glass slides and sectioned at 5 µm thickness. These FFPE slides can be used to perform RNA scope ISH, FISH IF, IHC and NGS, etc.
Showing all 15 results
-

Human Breast Cancer, ER+/PR+/Her2 (+), (Invasive ductal carcinoma) FFPE Sections
SKU: HuPS-02005T $139.99 -

Human Breast Cancer, Triple Positive (ER+/PR+/Her2+), (Invasive duct carcinoma) FFPE Sections
SKU: HuPS-02006T $139.99 -

Human Breast Cancer, Triple Positive (ER+/PR+/Her2+), (Invasive duct carcinoma) FFPE Sections
SKU: HuPS-02007T $139.99 -

Human Breast Cancer, Triple Positive (ER+/PR+/Her2+), (Invasive duct carcinoma) FFPE Sections
SKU: HuPS-02008T $139.99 -

Human Breast Cancer, Triple Positive (ER+/PR+/Her2+), (Invasive duct carcinoma) FFPE Sections
SKU: HuPS-02009T $139.99 -

Human Breast Cancer, Triple Positive (ER+/PR+/Her2+), (Invasive duct carcinoma) FFPE Sections
SKU: HuPS-02010T1 $139.99 -

Human Breast Cancer, Triple Positive (ER+/PR+/Her2+), (Invasive duct carcinoma) FFPE Sections
SKU: HuPS-02010T2 $139.99 -

Human Breast Cancer, Triple Positive (ER+/PR+/Her2+), (Infiltrating duct carcinoma) FFPE Sections
SKU: HuPS-02011T $139.99 -

Human Breast Cancer, Triple Positive (ER+/PR+/Her2+), (Infiltrating duct carcinoma) FFPE Sections
SKU: HuPS-02012T $139.99 -

Human Breast Cancer, Triple Positive (ER+/PR+/Her2+), (Invasive high grade mammary CA with medullary features) FFPE Sections
SKU: HuPS-02013T $139.99 -

Human Breast Cancer, Triple Positive (ER+/PR+/Her2+), (Multifocal infiltrating duct carcinoma) FFPE Sections
SKU: HuPS-02014T $139.99 -

Human Breast Cancer, Triple Positive (ER+/PR+/Her2+), (Infiltrating duct carcinoma) FFPE Sections
SKU: HuPS-02015T $139.99 -
Human Breast Cancer, Triple Positive (ER+/PR+/Her2+), (Invasive lobular carcinoma ) FFPE Sections
SKU: HuPS-02032T1 $139.99 -

Human Breast Cancer, Triple Positive (ER+/PR+/Her2+), (Invasive ductal carcinoma ) FFPE Sections
SKU: HuPS-02034T $139.99 -

Human Breast Cancer, Triple Positive (ER+/PR+/Her2+), (Invasive ductal carcinoma ) FFPE Sections
SKU: HuPS-02035T $139.99
Showing all 15 results
